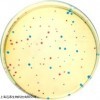

公司简介
上海远慕生物科技有限公司是一家集研发、销售、定制合 成于一体的专业试剂公司,我们的团队由具有资深行业背景和丰富市场经验的专业人士组成,致力于向国内外相关大专院校和科研机构提供高品质的化学产品,我司 既能满足研发类客户对产品种类、包装、纯度的特殊要求,也能满足企业从小试、中试到规模化的各个阶段的综合需求。
展开
产品说明
中文名称:
植物ChIP试剂盒(24次分析)
英文名称:EpiQuik Plant ChIP Kit (24 reactions)
规格:24 reactions
品牌:Epigentek
植物ChIP试剂盒(24次分析)产品描述
EpiQuik 植物染色质免疫共沉淀(ChIP)试剂盒提供了对植物细胞样品进行染色质免疫沉淀反应所需的所有试剂.并且,试剂盒中还有一种ChIP级二甲基组蛋白H3-K9抗体和一种阴性对照抗体(正常小鼠的IgG).从细胞样品中提取出来的染色质进行适当的打断,然后加入到微孔中与其表面上吸附的抗体发生免疫反应.特异性结合到微孔上的DNA从抗体-捕获蛋白-DNA复合物上释放出来,翻转后,通过本公司专门设计的高速离心柱纯化.洗脱下来的DNA可用于随后的各种分析.该植物染色质免疫沉淀(ChIP)试剂盒 内主要产品组份包括:CP1 (Wash Buffer) CP2 (Antibody Buffer) CP3C (5X Lysis Buffer I) CP3D (Lysis Buffer II) CP3E (Lysis Buffer III) CP3F (Lysis Buffer IV) CP4 (ChIP Dilution Buffer) CP5 (DNA Release Buffer) CP6 (Reverse Buffer) CP7 (Binding Buffer) CP8 (Elution Buffer) Protease Inhibitor Cocktail (100X) Normal Mouse IgG (1 mg/ml) Anti-Dimethyl H3-K9 (1 mg/ml) Proteinase K (10 mg/ml) 8-Well Assay Strips (with f
rame) 8-Well Strip Caps F-Spin Column F-Collection Tube 用户指南手册
植物ChIP试剂盒(24次分析)产品特点
1、市场上同类产品中最快捷的试剂盒,整个处理过程不到6小时;
2、96孔板模式使研究人员能根据自己需要选择手工或是高通量分析;
3、附有DNA纯化柱子:大量减少不必要的重复劳动;
4、操作简便、结果可靠、统一的分析条件;
保存建议:请在您收到Epigentek的植物染色质免疫沉淀(ChIP)试剂盒 (24次反应)产品后,参考说明书建议,使用不同的保存条件或温度来保存试剂盒内组分.
其他: Epigentek 公司是全球领先的表观遗传学相关研究的技术创新者和产品开发供应商。开发了超过700多个专利产品,为表观遗传学方面的研究和新药研发提供全面系统的解决方案,涵盖样品制备、DNA/RNA甲基化(5-mc, 5-hmc, 5-fc, m6A)/DNMT分析、ChIP、组蛋白甲基化/乙酰化/去乙酰化/磷酸化/SUMO-等领域,提供小分子抑制剂、蛋白质、抗体、以及分析试剂盒产品。
本页产品地址:http://www.geilan.com/sell/show-9356217.html

![]()

 免责声明:以上所展示的[ 植物ChIP试剂盒(24次分析)]信息由会员[上海远慕生物科技有限公司]自行提供,内容的真实性、准确性和合法性由发布会员负责。
免责声明:以上所展示的[ 植物ChIP试剂盒(24次分析)]信息由会员[上海远慕生物科技有限公司]自行提供,内容的真实性、准确性和合法性由发布会员负责。